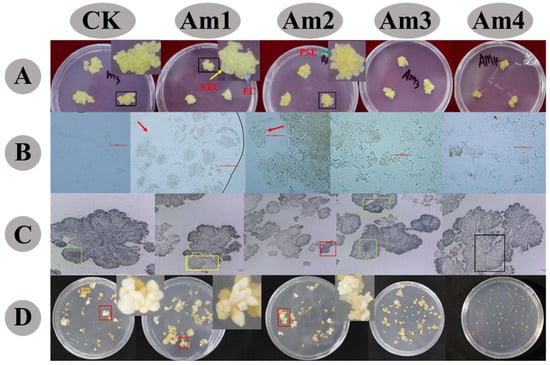

Abstract
Amino acids (AAs) are important regulators of morphogenesis during somatic embryogenesis. This study investigated the roles of AAs in callus proliferation and embryo induction in Litchi chinensis Sonn. cv. ‘Feizixiao’ to improve the current in vitro regeneration protocols toward supporting efficient commercial litchi propagation and breeding programs. During callus proliferation, the total AAs ranged from 4627.9 μg·gFW−1 on day 3 to 7827.8 μg·gFW−1 on day 21, with an average content of 5994.0 μg·gFW−1. The total AA content continuously decreased to 3390.1 μg·gFW−1 on day 10 and slightly increased between days 10 and 20 during embryo induction, with an average content of 4849.7 μg·gFW−1. At both stages, γ-aminobutyric acid, arginine, alanine, and glutamine accounted for more than 10% of the total AAs, and methionine, tryptophan, glycine, and cystine contents were lower than 1%, except for the tyrosine content, which was also lower than 1% at the embryo induction stage. The callus proliferated on medium supplemented with a low concentration of AMO1 solution, a mixture of 21 amino acids prepared according to the average proportion of each amino acid during callus proliferation. The calli were small, yellow, and uniform, with deep Ehrlich hematoxylin staining. When cultured on medium containing a high concentration of AMO1, the callus gradually turned brown, with more dark yellow proembryos, and cell lysis and apoptosis occurred. The combination of adding 4× AMO1 solution to the proliferation medium and adding 1× AMO2 solution, which was mixed with 21 amino acids according to their average proportion during embryo induction, to the embryo induction medium had the best regeneration efficiency, with about 396 embryos and 88 regenerated plantlets per gram of callus. The results provide a basis for the rational combined application of AAs during the in vitro regeneration of litchi to achieve greater somatic embryogenesis efficiency.
1. Introduction
Litchi (Litchi chinensis Sonn.) is a commercially grown subtropical and tropical fruit in China that is rich in nutrients with a sweet and crispy aril, earning it a reputation as a “treasure of China” [1]. The litchi industry has developed rapidly in recent years, and the demand for excellent new cultivars has increased. Traditional breeding techniques have limitations such as long reproductive cycles, high costs, and low efficiency, while molecular breeding has advantages such as short breeding cycles and the rapid improvement of targeted traits, making it a promising approach for the selection and breeding of new litchi cultivars [2]. An efficient in vitro regeneration technology system is a prerequisite for molecular breeding, and somatic embryogenesis is the key to in vitro regeneration [3,4,5]. Somatic embryogenesis is the most effective technique for the large-scale propagation of plants and the long-term conservation of different embryogenic cell lines. However, for many species, in vitro clonal propagation is currently difficult or inefficient. The low efficiency of somatic embryo induction is among the major problems hindering efficient regeneration and limiting practical applications. Therefore, high-quality somatic embryo production is one of the most important factors in somatic embryogenesis protocols for commercial propagation and breeding programs [6,7].
Numerous studies have shown that amino acids (AAs) can promote plant growth and development as organic nitrogen sources [8], play significant roles in plant cells and tissues [9,10], and are important regulators in vitro [11,12]. Most of the existing studies have focused on the effects of a single or a small number of major AA mixtures, such as glutamine (Gln), glycine (Gly), and proline (Pro) [13,14,15,16]. However, there are more than 20 kinds of AAs in plants, and the interactions between these AAs maintain plant growth and development. Treatment with a small number of exogenous AAs may not reflect the effect of the combination of multiple AAs on in vitro regeneration.
There are few reports on the effects of Gln, glutamic acid (Glu), casein hydrolysate (CH), or lactalbumin hydrolysate (LH) on callus proliferation and the somatic embryogenesis of litchi [4,17,18,19]. Furthermore, there have been no reports on the changes in AA content during callus proliferation and somatic embryo induction, and the effect of exogenous AAs on litchi in vitro regeneration has not been reported. Hence, this study investigated the changes in various amino acids during the proliferation of the litchi callus and somatic embryogenesis. The effects of combinatorial AAs during callus proliferation and somatic embryogenesis were studied by adding a variety of AA mixtures to the medium. The results provide a basis for the efficient somatic embryogenesis of litchi and for the rational application of AAs during in vitro regeneration.
2. Materials and Methods
2.1. Callus Induction and Culture
Embryogenic calli (ECs) of ‘Feizixiao’ were initiated by anthers on M1 medium (Table 1), and the anthers were obtained from the Institute of Tropical Fruits, Hainan Academy of Agricultural Sciences, Hainan province, China. ECs were subcultured on M3 medium and M4 medium (Table 1), with the media alternated every 30 days [3].

Table 1.
Composition of media used in this study [3].
Calli that had been subcultured on M3 medium for 0, 3, 6, 9, 12, 15, 18, 21, and 24 days were collected, frozen in liquid nitrogen (N2), and stored at −80 °C for the analysis of AA contents.
Calli were transferred to T3 medium (Table 1) [3] for embryo induction. Cultures at days 0, 5, 10, 15, and 20 were sampled, frozen in liquid N2, and stored at −80 °C for the analysis of AA contents.
- Experiment 1
2.2. AA Quantification Using High-Performance Liquid Chromatography (HPLC)
The AAs were extracted using a solution of 0.1 mol·L−l hydrochloric acid (HCl). Frozen calli weighing 0.5 g were soaked in 4.5 mL of precooled HCl. Then, the macerated samples were extracted ultrasonically for 40 min at 4 °C and centrifuged at 10,000× g for 10 min, after which 0.3 mL of supernatant was transferred to 2-mL Eppendorf tubes, and 75 µL 0.1 mol·L−1 phenyl isothiocyanate feniltiocarbamil (PITC)-acetonitrile and 75 µL 1 mol·L−1 triethylamine-acetonitrile were added. After being vortexed for 1 min, the mixture was incubated at 4 °C in cool water for 60 min. A volume of 1.4 mL of n-butane was added to the mixture and vortexed for 30 s. It was left to stand for 2 min and centrifuged at 10,000× g for 5 min. The mixture was extracted twice by removing the supernatant and extracting it again with n-butane. The supernatant was filtrated through 0.22-µm membrane filters. The standard sample was also derived before the assay.
HPLC analysis of AA was performed on a Waters e2695 Separations Module HPLC System attached to a PDA 2998 model (Agilent, Santa Clara, CA, USA) following the method of Dhillon et al. [20]. The HPLC separation conditions were set at a temperature of 35 °C and a solvent flow of 1 mL·min−1 (solvent A: 95% sodium acetate buffer; solvent B: acetonitrile, methanol, and water at a ratio of 6:2:2). The derivatized AAs were eluted with an increase in the proportion of the organic phase.
The above experiments were repeated three times. The data recorded for analysis were the mean values. The concentration of each AA was calculated by comparing the peak areas with an external standard of a known concentration. The total amino acid (TAA) concentrations were obtained through the summation of the individual AA concentrations (Table 2 and Table 3).

Table 2.
Amino acid (AA) content (μg·gFW−1) during callus proliferation in Feizixiao litchi.

Table 3.
Amino acid (AA) content during somatic embryogenesis of Feizixiao litchi (μg·gFW−1).
- Experiment 2
2.3. The Addition of AAs to the Proliferation Medium
AMO1, a solution containing 21 amino acids according to their average percentage in the callus during proliferation, was prepared. The solution had a TAA content of 20%. In the first set of experiments, ECs were cultivated on M3 medium supplemented with 1×, 5×, 10×, or 15× AMO1 (Table 4) and marked as Am1, Am2, Am3, and Am4, respectively, for three weeks of culture. The proliferation rate was then calculated. The ECs were subcultured on embryo induction medium (T3, Table 1) for seven weeks, and the yields of embryos from each treatment were counted and calculated as yields per gram of fresh EC.

Table 4.
The concentrations of amino acid (AA) mixtures.
Based on the above results, in the second set of experiments, ECs were cultivated on M3 medium supplemented with 1×, 2×, 3×, 4×, or 5× AMO1 and marked as Am1, Am5, Am6, Am7, and Am2, respectively, for three weeks and then further subcultured on embryo induction medium (T3, Table 1) for seven weeks. The EC proliferation rate and the number of somatic embryos were also calculated.
M3 medium, including all the above ingredients except for the AAs, served as a control.
The proliferation index of ECs was obtained using the following formula:
Proliferation index of EC = (callus tissue mass on day 21 − callus tissue mass on day 0)/callus tissue mass on day 0.
Somatic embryos induced by the above treatments were transferred onto C19 medium (Table 1) for maturation. After eight weeks, somatic embryos were transferred to R7 medium for germination (Table 1). The yields of plantlets formed per gram of fresh weight of EC were counted after six weeks of incubation in the light. The light intensity was set to 50 μmol−1m2·s−1, with a 16 h day length.
2.4. Histology of AMO1-Proliferated Callus
The dead or living cells of ECs in different proliferation media were detected by Trypan Blue [21], and the EC morphology was examined by Ehrlich hematoxylin. The ECs were fixed in FAA (volumes of 38% formaldehyde, acetic acid, and 70% ethanol = 1:1:18), dehydrated in a graded aqueous ethanol series (70, 85, 95, and 100%), and embedded in paraffin. Each sample was sectioned serially at 8 µm on a microtome (Leica RM2016, Tokyo, Japan). Subsequently, sections were stained with Ehrlich hematoxylin using the method described in a previous report [22]. The prepared slides were observed and photographed using a light microscope (NI/E, Nikon, Tokyo, Japan).
- Experiment 3
2.5. The Addition of AA to the Somatic Embryo Induction Medium
Based on the results of experiment 2, ECs cultured on M3 medium and M3 medium supplemented with 4× or 5× AMO1 for three weeks were transferred to T3 medium or T3 medium supplemented with 1×, 5×, 10×, or 15× AMO2 (a solution containing 21 amino acids, where the proportion of each amino acid was the same as the average amount in the callus during somatic embryo induction, and a TAA content of 20%), respectively (Table 4, the treatments coded as CK, M3Az1, M3Az2, M3Az3, M3Az4, Am7T3, Am7Az1, Am7Az2, Am7Az3, Am7Az4; Am2T3, Am2Az1, Am2Az2, Am2Az3 and Am2Az4) for the next seven weeks. This experiment was conducted to optimize the combination and concentrations of AMO1 and AMO2 for efficient induction of somatic embryos.
The conditions of somatic embryo maturation and regeneration were as described in Section 2.3.
2.6. Data Analysis
For callus proliferation, 30 dishes were used in each experiment, and five dishes were set as replicates. The mean percentage of callus proliferation was calculated over three weeks of incubation. For somatic embryo induction, 120 dishes of ECs were used in one treatment, with 20 dishes as a replicate. For the regeneration of somatic embryos, 180 mature somatic embryos of 0.5–1.0 mm in diameter were used. One repeat was set with 60 embryos. The mean number of regenerated shoots per embryogenic callus was calculated after six weeks. For statistical analysis, the data were analyzed, and the mean values were compared using one-way analysis of variance (ANOVA). The significance of variations within means was determined at p = 0.05 using Duncan’s multiple range test in the DPS software (version 2, Hangzho, China) [23].
3. Results
3.1. AA Contents during Callus Proliferation
There were 21 AAs in the callus during proliferation and embryo induction. The contents and proportions of each AA were different (Table 2 and Table 3). The percentages of γ-aminobutyric acid (GABA), alanine (Ala), arginine (Arg), and Gln were greater than 10%, and the proportions of cysteine (Cys), Gly, tryptophan (Trp), and methionine (Met) were less than 1%. The ratios of most AAs (Pro, leucine (Leu), Glu, phenylalanine (Phe), isoleucine (Ile), valine (Val), serine (Ser), aspartic acid (Asp), threonine (Thr), lysine (Lys), asparagine (Asn), histidine (His), and tyrosine (Tyr)) were between 1% and 10%.
The Tyr ratio was reduced during somatic embryogenesis, finally being less than 1%.
The average content of TAA was 5994.0 μg·gFW−1 during callus proliferation. This value decreased and reached the lowest content of 4627.9 μg·gFW−1 on day 3, and gradually increased from day 15 to 21, reaching a peak of 7827.8 μg·gFW−1 on day 21, after which the TAA content decreased.
The change in GABA and Ala contents was similar to the change in TAAs, and the highest and second-highest contents were reached on days 12 and 21. The GABA content was the lowest on day 3 at 855.3 μg·gFW−1, and decreased continuously from day 15 to day 18. The Ala content continued to rise from day 0 to day 12 and reached its lowest point on day 24 at 641.9 μg·gFW−1. The lowest content of Arg was 416.5 μg·gFW−1 on day 3. The Arg content slowly increased from day 3 to day 15, sharply increased from day 15 to day 18, and reached the highest content of 1348.5 μg·gFW−1 on day 18. The content of Gln first decreased, then increased and decreased again, reaching the lowest and highest contents of 403.7 μg·gFW−1 and 822.1 μg·gFW−1, on days 6 and 15, respectively.
The following AAs were detected at low concentrations: Met, Trp, Gly, and Cys. Met had the lowest average (24.0 μg·gFW−1) and accounted for only 0.4% of the average among the TAAs. The Met, Trp, and Gly contents all increased and then decreased, followed by a second increase and another decrease.
Most of the AAs with contents greater than 1% but less than 10% (Table 2), including Pro, Leu, Glu, Thr, Tyr, His, Asn, and Lys, decreased, then increased and decreased, and increased and decreased again. The Ile and Phe contents showed two changes: the levels first increased and then decreased, followed by a second increase and another decrease. The Ser slightly decreased to its lowest content on day 3 and subsequently showed an increase and then a decrease, followed by a second increase and another decrease. The Val content varied greatly.
3.2. AA Contents during Somatic Embryo Induction
The average content of TAA was 4849.7 μg·gFW−1 during embryo induction. The highest TAA content (6732.4 μg·gFW−1) was detected in the callus that had just been transferred to the embryo induction medium, and the lowest content was detected in the callus on day 10 (3390.1 μg·gFW−1).
The changes in the GABA, Arg, Gln, and Ala contents were the same as the changes in TAAs. These contents were all at their highest point on day 0 and then decreased to their lowest contents on day 10, after which the values rose again to reach a peak on day 15. However, the GABA, Gln, and TAA contents decreased, while the contents of Arg and Ala continued to rise after day 15.
Five AAs (Met, Trp, Gly, Cys, and Tyr) contributed less than 1% to the TAAs (Table 3). The lowest was Met (14.2 μg·gFW−1), accounting for only 0.3% of the TAA content. The changes in Met, Trp, Gly, and Tyr, whose contents contributed less than 1% to the TAAs, were the same as the change in Arg content. These contents were all at their highest point at day 0, then decreased and increased.
The contents of 12 AAs that contributed between 1% and 10% of the TAAs showed three trends (Table 3). The first trend was to decrease and then rise, which was found in three AAs: Lys, Pro, and Phe. The second trend was to decrease and then rise, then decrease again, which was observed in seven AAs: Asp, Asn, Ser, Thr, Ile, His, and Val. The third trend was to rise and then decrease, then rise and decrease again, which was detected in Glu.
3.3. Effects of AMO1 on the Callus Proliferation Index and Somatic Embryo Induction and Regeneration
To determine whether AAs affected the in vitro regeneration of litchi, the numbers of somatic embryos and regenerated plants per gram of FW at various AA concentrations were measured. The results showed that the proliferation index of EC and the numbers of somatic embryos and regenerated plants were dependent on AA concentrations and increased significantly with the addition of 5× AMO1 (Figure 1).

Figure 1.
Effects of varied concentrations of AMO1 on callus proliferation, somatic embryo induction, and regeneration. (A): Embryonic callus (EC) proliferation index on proliferation medium supplemented with different concentrations of AMO1 after three weeks. (B): Mean number of somatic embryos formed per gram of callus calculated after seven weeks of induction in the dark. (C): Mean number of regenerated plantlets calculated after eight weeks of incubation in the light. Values represent the mean ± standard deviation of three replicates. Means marked with the same lowercase letter are not significantly different within the treatments, according to Duncan’s multiple range test (p < 0.05).
The concentration of 5× AMO1 resulted in the highest EC proliferation index at 9.8-fold (Figure 1A), 350 somatic embryos (Figure 1B), and 63 regenerated plants per callus (Figure 1C). By contrast, when the AMO1 concentration increased to 10×, the EC proliferation index was lower than that of the control (without AMO1). A large number of transparent embryos were induced in 10× AMO1, with only a small number of milky embryos being induced (Figure 2D, Table 5). All the transparent embryos turned brown and eventually died off. Therefore, adding a low concentration of AMO1 to the proliferation medium can improve the EC proliferation index and the numbers of somatic embryos and regenerated plants.
Figure 2.
Effects of amino acids on callus proliferation and somatic embryogenesis. ECs: embryogenic calli; NECs: non-embryogenic calli; PEs: proembryos. (A): Callus morphology; blue arrow indicates the EC; yellow arrow indicates NECs; green arrow indicates PEs. (B,C): Callus histology, (B): Scale bar = 50 μm; the red arrow indicates the dividing cell. (C): Scale bar = 100 μm; green borders indicate the PEs; yellow borders indicate the NECs; red borders indicate ECs; black borders indicate apoptotic cells. (D): Somatic embryogenesis on T3 medium after seven weeks; the red borders indicate the cotyledonous embryo.

Table 5.
Effects of amino acids on callus proliferation and somatic embryogenesis in Litchi chinensis Sonn. cv. Feizixiao.
The results indicated that the efficiency of embryo induction differed significantly among various AA concentration levels (Figure 3). The lowest result (8.1-fold callus proliferation index, 252 embryos, and 22 regenerated plants) was achieved in the control, which indicates that supplementation with AAs is essential for efficient callus proliferation, somatic embryogenesis, and regeneration. The best result was obtained at 4× AMO1 concentration (374 embryos and 80 regenerated plants, Figure 3B,C). The number of somatic embryos at an AMO1 concentration below 5× was higher than that of the control, and the number of somatic embryos increased as the AMO1 concentration increased. The somatic embryos induced on the medium with AMO1 were bright milky white, and the volume of dicotyledonous embryos increased with higher AMO1 concentrations, while most of the smaller embryos were globular (Figure 4D, Table 6). The mature somatic embryos induced under different AMO1 concentrations were plump. The somatic embryos appeared pink or crimson-red under light (Figure 5A). The embryos slowly became green and regenerated. Most were multi-stem embryos in the medium supplemented with AAs (Figure 5B, red border). The stems were bright green, and the buds were white (Figure 5B, yellow border). The addition of more AMO1 increased the number of transparent embryos. There were some transparent embryos in the control and the 1× AMO1 concentration, and no transparent embryos were induced under 2×, 3×, and 4× AMO1 (Figure 2 and Figure 3). However, a larger number of transparent embryos were induced under 5× AMO1.

Figure 3.
Effects of different concentrations of AMO1 on callus proliferation, somatic embryo induction, and regeneration. (A): Embryogenic callus (EC) proliferation index on different media after three weeks. (B): Mean number of somatic embryos formed per gram of callus calculated after seven weeks of incubation in the dark. (C): Mean number of regenerated plantlets calculated after eight weeks of incubation in the light. Values represent the mean ± standard deviation of three replicates. Means marked with the same lowercase letter are not significantly different within the treatments, according to Duncan’s multiple range test (p < 0.05).

Figure 4.
Effects of amino acids on callus proliferation and somatic embryogenesis. (A–C): Embryogenic callus (EC) proliferation index on different media after three weeks. (B): Scale bar = 50 μm; the red arrow indicates the multicellular embryos. (C): Scale bar = 100 μm; green border indicates ECs; yellow border indicates proembryos. (D): Somatic embryogenesis on T3 medium after seven weeks; the red border indicates the cotyledonous embryo.

Table 6.
Effects of amino acids on callus proliferation and somatic embryogenesis in Litchi chinensis Sonn. cv. Feizixiao.

Figure 5.
Effects of different amino acids on somatic embryogenesis induction and generation. (A): Mature dicotyledonous embryo bordered in red. (B): Red border: multi-stem embryos. Yellow border: Fresh white tips. (C): Regenerated plantlets.
3.4. Histological and Morphological Changes
The observations to this point have shown that AMO1 can accelerate the proliferation of calli. However, whether these calli showed normal structural development needed to be determined. Hence, calli from the control and those treated with AMO1 at varied amounts (1×, 5×, 10×, and 15×) were subjected to histological observations. After three weeks of induction, the EC particles became smaller (Figure 2A, blue arrow), and there was some proembryo differentiation with the increase of AMO1 (Figure 2, green arrow).
The boundary was obvious and easier to distinguish between ECs and non-embryogenic calli (NECs) (Figure 2A, yellow arrow). The cells became round and full, with more vigorous division as the amount of AMO1 added increased (Figure 2B, red arrow). Histological observations showed that the calli on the medium with less than 5× AMO1 contained more embryonic cells with a smaller size and deeper staining. Embryonic cells were evenly sized, with thicker cytoplasm and deeper staining (Figure 2C, red border), while non-embryonic cells were lysed, with lighter staining (Figure 2C and Figure 4C, yellow border). With the increase in the amount of AMO1, only a small number of multicellular embryos were observed (Figure 2C and Figure 4C, green border), and embryonic cells divided vigorously without non-embryonic cells.
The calli proliferation on the medium with high concentrations (10× or 15×) of AMO1 was inhibited (Figure 1A). The calli became brown, and the particles became thicker with more proembryonic differentiation (Figure 2A). Morphological observations showed that the cells underwent apoptosis, with only a small number of round cells observed (Figure 2B). Histological observations showed that the non-embryonic cells had lysed, and the embryonic cells exhibited more severe lysis and darker staining with the increase of AMO1 (Figure 2C, black border).
3.5. Effects of the Combination of AMO1 and AMO2 on Somatic Embryogenesis and Regeneration
ECs from 4× and 5× AMO1 proliferation medium were transferred to the embryo induction medium supplemented with different amounts of AMO2 to detect the effect of the AMO2 concentration on the embryo induction efficiency. As shown in Table 7, Figure 6 and Figure 7, the control exhibited the lowest number of embryos (243 embryos) and regenerated plantlets (23 plantlets) per gram of callus. The number of embryos (297 embryos) and regenerated plantlets (41 plantlets) peaked at a concentration of 1× AMO2, while a higher amount of AMO2 lowered the number of embryos and plantlets.

Table 7.
Effects of amino acids on somatic embryogenesis in Litchi chinensis Sonn. cv. Feizixiao.

Figure 6.
Effects of different combinations of AMO1 and AMO2 on somatic embryogenesis. (A): Mean number of somatic embryos formed per gram of callus calculated after seven weeks of induction in the dark. (B): Mean number of regenerated plantlets calculated after eight weeks of incubation in the light. Values represent the mean ± standard deviation of three replicates. Means marked with the same lowercase letter are not significantly different within the treatments, according to Duncan’s multiple range test (p < 0.05).

Figure 7.
Effects of different combinations of AMO1 and AMO2 on somatic embryo induction.
The results of the addition of 4× AMO1 to the proliferation medium showed that a greater number of embryos and plantlets per gram of callus was found in the absence of AMO2 (374 embryos and 80 plantlets), and the AMO2 peaked at 1× AMO2 (396 embryos and 88 plantlets) but decreased with the addition of 5× AMO2 (122.0 embryos) or more to the induction medium.
The results of the addition of 5× AMO1 to the proliferation medium showed that the number of embryos and plantlets per gram of callus achieved in the absence of AMO2 were 338 and 51, respectively. Greater amounts of AMO2 added to the induction medium decreased the number of somatic embryos and regenerated plants. The number of induction embryos differed significantly with the addition of varied concentrations of AMO2 to the induction medium.
4. Discussion
In this study, we found that TAA content during embryo induction was lower than that during callus proliferation, indicating that somatic embryo induction requires more AAs. The reduced contents of Ala and GABA accounted for more than 20% of the total decrease, indicating that Ala and GABA were the major AAs. Previous research has confirmed this result. The combination of Ala, GABA, and Gln can significantly improve the efficiency of somatic embryo induction and germination [24]. This study further shows that a full AA mixture can provide comprehensive amino acid substances, a treatment that is more conducive to lychee somatic embryo induction, especially by adding the 4× AMO1 mixture to the proliferation medium and the 1× AMO2 mixture to the somatic embryo induction medium (Table 7 and Figure 6). Similar results were reported in Pinus patula, where the addition of an AA mixture accelerated somatic embryo induction [25]. One possible explanation for the rapid induction of somatic embryos by AAs is that, as an important nitrogen source, AAs can improve early callus morphology (Figure 2B,C and Figure 3B,C), thus regulating the synchronization of somatic embryos and promoting somatic embryo induction and germination [12]. Another explanation would be that the acquisition of embryogenic competence is a stressful process, and AAs normally accumulate under stress [26,27].
Induction of embryogenesis and embryonic development were strictly dependent on the type and concentration of amino acids in the medium. Rahmouni et al. [9] found that Gln and Asn at 3.42 mM were the most favorable for the formation of functional somatic embryos and the induction of secondary somatic embryos in Moroccan cork oak (Quercus suber L.). Martinez et al. [28] found that Gln decreased the number of nodular embryogenic structures and secondary somatic embryos in Quercus ilex. Von Arnold [29] found strong negative effects of Gln, Arg, and Asn on the induction of somatic embryogenesis in Picea abies. Changes in the somatic embryo phenotype could be induced by adding amino acids to the medium [30]. Pinto et al. [31] found that the addition of CH and Gln increased the formation of abnormal embryos in Eucalyptus globules. Moreover, in Picea glauca, organic nitrogen had a negative effect on somatic embryo maturation [32]. The inconsistent results may be due to different sensitivities to exogenous AAs caused by different culture systems or plant species.
Some studies have shown that mixtures of AAs are more effective in promoting SE than single AAs. Daniel et al. [33] found that mixed AAs (0.3 g·L−1 Gln and 0.4 g·L−1 CH) were more effective in promoting okra embryogenesis, maturation, and germination than the application of a single AA (Ser, Pro, or Gln) at concentrations of 0.1–0.3 g·L−1. Ashok et al. [34] compared the effects of five AAs (Gln, Gly, Arg, Asn, and Cys) at four concentration levels (0.5, 1.0, 2.0, and 5.0 mM) on somatic embryo induction and regeneration in two cucumber varieties. They found that the application of 2 mM single AAs promoted embryo induction, while the application of 0.5 or 5.0 mM single AAs did not increase embryo induction. A mixture of five AAs (each at a concentration of 1.0 mM) was more effective than the application of a single AA, and 5.0 mM mixed AAs were more effective than 10 mM. Pintos et al. [35] found that a mixture of three AAs (Gln, Arg, and Asn) or GABA alone could promote embryonic development, while these three AAs alone did not significantly promote embryo induction. Kong et al. [36] found that a mixture of AAs (685 μM Gln, 574 μM Arg, and 667 μM Asn) promoted coconut callus formation. Maruyama et al. [37] found that the AAs mixture (Major AA: 2 g·L−1 Glu, 1 g·L−1 Asp, and 0.5 g·L−1 Arg; Minor AA: 0.158 g·L−1 citrulline (Cit), 0.152 g·L−1 Orn, 0.11 g·L−1 Lys, 0.08 g·L−1 Ala, 1 g·L−1 Asp, and 0.5 g·L−1 Arg) significantly promoted embryo maturation and increased the number of mature cotyledon embryos by more than 27 times. A study by Malabadi et al. [25] revealed that a 10 mM mixture of 17 AAs had the greatest effect on the induction and maturation of Pinus patula. Thus, AA mixtures are more effective than the application of single AAs or a mixture of a small number of AAs. An excess or deficiency of AAs is harmful to embryo induction, which may be related to the types, proportions, and interconversion of AAs. This is consistent with the results of this study using a full mixture of AAs. In this study, the AMO1 and AMO2 mixtures containing 21 AAs added to the callus proliferation and embryo induction media significantly promoted litchi SE and germination.
In general, AAs promote somatic embryogenesis in litchi, which is of great significance for somatic embryogenesis in woody trees. These results provide evidence that AAs can strongly affect somatic embryogenesis, perhaps as a supplement to the regulatory effects observed for the more widely studied role of plant hormones in this process. Further studies are needed to investigate the roles of single AAs and explore molecular mechanisms underlying the roles of AAs in SE. This work may benefit the improvement of somatic embryogenesis protocols by using AAs and lays a foundation to investigate the molecular mechanism through which AAs regulate somatic embryo induction and development.
5. Conclusions
In summary, this study revealed that GABA, Arg, Ala, and Gln were the main AAs in litchi calli. AAs had a positive effect on the induction of litchi somatic embryos. In the process of callus proliferation and somatic embryogenesis, mixtures of 21 AA with different proportions could significantly promote the regeneration of litchi. When 4× AMO1 mixtures of 21 AAs were added to proliferation medium and 1× AMO2 mixtures of 21 AAs were added to somatic embryo induction medium, 396 embryos and 88 plantlets per gram of callus were obtained. This study provides a research basis and technical approach for further research on the in vitro regeneration of litchi. However, the role of each AA in callus proliferation and somatic embryogenesis remains to be further studied.
Author Contributions
J.W. conceived and designed the experiments. G.W. and Y.L. performed the experiments. G.W. analyzed the data and wrote the manuscript. H.L. and Z.G. contributed reagents, materials, and analytical tools. All authors have read and agreed to the published version of the manuscript.
Funding
This research was funded by grants from the National Key R&D Program of China (2019YFD1000900) and the earmarked fund for CARS (CARS–32).
Institutional Review Board Statement
This article does not contain any studies with human participants or animals performed by any of the authors.
Data Availability Statement
The original contributions presented in the study are included in the article. Further inquiries can be directed to the corresponding author.
Acknowledgments
We thank pre-submission expert review.
Conflicts of Interest
The authors declare no conflict of interest.
References
- Hu, G.B.; Feng, J.T.; Xiang, X.; Wang, J.B.; Jarkko, S.; Liu, C.M.; Wu, Z.X.; Zhang, J.S.; Liang, X.M.; Jiang, Z.D.; et al. Two divergent haplotypes from a highly heterozygous lychee genome suggest independent domestication events for early and late-maturing cultivars. Nat. Genet. 2022, 54, 73–83. [Google Scholar] [CrossRef] [PubMed]
- Das, D.K.; Rahman, A. Expression of a bacterial chitinase (ChinB) gene enhances antifungal potential in transgenic Litchi Chinensis Sonn. (Bedana). Curr. Trends Biotechnol. Pharm. 2010, 4, 820–833. [Google Scholar]
- Wang, G.; Li, H.L.; Wang, S.J.; Sun, J.H.; Zhang, X.C.; Wang, J.B. In vitro regeneration of litchi (Litchi chinensis Sonn.). Afr. J. Biotechnol. 2016, 15, 1026–1034. [Google Scholar] [CrossRef]
- Das, D.K.; Rahman, A.; Kumari, D.; Kumari, N. Synthetic seed preparation, germination and plantlet regeneration of Litchi (Litchi chinensis Sonn.). Am. J. Plant Sci. 2016, 7, 1395–1406. [Google Scholar] [CrossRef][Green Version]
- Anjani, K.; Kumar, H. In vitro studies in Litchi chinensis–effect of explant and medium. Int. J. Curr. Microbiol. Appl. Sci. 2018, 7, 2413–2422. [Google Scholar] [CrossRef]
- Yu, C.; Chen, Z.; Lu, L.; Lin, J.W. Somatic embryogenesis and plant regeneration from litchi protoplasts isolated from embryogenic suspensions. Plant Cell Tissue Organ Cult. 2000, 61, 51–58. [Google Scholar] [CrossRef]
- Puchooa, D. In vitro regeneration of lychee (Litchi chinensis Sonn.). Afr. J. Biotechnol. 2004, 3, 576–584. [Google Scholar]
- He, Y.Q.; Cheng, J.P.; He, Y.; Yang, B.; Cheng, Y.H.; Yang, C.; Zhang, H.S.; Wang, Z.F. Influence of isopropyl malate synthase OsIPMS1 on seed vigor associated with amino acid and energy metabolism in rice. Plant Biotechnol. J. 2019, 17, 322–337. [Google Scholar] [CrossRef]
- Rahmouni, S.; Ansari, Z.N.E.; Badoc, A.; Martin, P.; Kbiach, M.L.E.; Lamarti, A. Effect of amino acids on secondary somatic embryogenesis of Moroccan Cork Oak (Quercus suber L.). Tree. Am. J. Plant Sci. 2020, 11, 626–641. [Google Scholar] [CrossRef]
- Bai, M.Y.; Lv, S.S.; Xia, X.Y. Effects of γ-aminobutyric acid on the growth and related physiological characteristics of Vaccinium plantlets in vitro. Plant Physiol. J. 2022, 58, 577–586. [Google Scholar] [CrossRef]
- Satish, L.; Rathinapriya, P.; Ceasar, S.A.; Rency, A.S.; Pandian, S.; Rameshkumar, R.; Subramanian, A.; Ramesh, M. Effects of cefotaxime, amino acids and carbon source on somatic embryogenesis and plant regeneration in four Indian genotypes of foxtail millet (Setaria italica L.). Vitr. Cell. Dev. Biol. Plant 2015, 52, 140–153. [Google Scholar] [CrossRef]
- Chen, T.T.; Yang, D.J.; Fan, R.F.; Zeng, R.H.; Lu, Y.; Chen, T.L.; Shi, J.S.; Chen, J.H. γ–Aminobutyric acid a novel candidate for rapid induction in somatic embryogenesis of Liriodendron hybrid. Plant Growth Regul. 2022, 96, 293–302. [Google Scholar] [CrossRef]
- Garin, E.; Bernier–Cardou, M.; Isabel, N.; Klimaszewska, K.; Plourde, A. Effect of sugars, amino acids, and culture technique on maturation of somatic embryos of Pinus strobus on medium with two gellan gum concentrations. Plant Cell Tissue Organ Cult. 2000, 62, 27–37. [Google Scholar] [CrossRef]
- Robichaud, R.L.; Lessard, V.C.; Merkle, S.A. Treatments affecting maturation and germination of American chestnut somatic embryos. J. Plant Physiol. 2004, 161, 957–969. [Google Scholar] [CrossRef] [PubMed]
- Ramakrishnan, M.; Ceasar, S.A.; Duraipandiyan, V.; Daniel, M.A.; Ignacimuthu, S. Efficacious somatic embryogenesis and fertile plant recovery from shoot apex explants of onion (Allium cepa. L.). Vitr. Cell. Dev. Biol. Plant 2013, 49, 285–293. [Google Scholar] [CrossRef]
- Asthana, P.; Rai, M.K.; Jaiswal, U. Somatic embryogenesis from sepal explants in Sapindus trifoliatus, a Plant Valuable in Herbal Soap Industry. Ind. Crops Prod. 2017, 100, 228–235. [Google Scholar] [CrossRef]
- Fu, L.F.; Tang, D.Y. Induction pollen plants of litchi tree (Litchi chinensis Sonn.). Acta Genet. Sin. 1983, 10, 369–374. [Google Scholar] [CrossRef]
- Fan, C.N.; Liu, G.J. Study on callus induction of litchi young leaves. China Fruits 2006, 03, 25–27. [Google Scholar] [CrossRef]
- Raharjo, S.H.T.; Litz, R.E. Somatic embryogenesis and plant regeneration of litchi (Litchi Chinensis Sonn.) from leaves of mature phase trees. Plant Cell Tissue Organ Cult. 2007, 89, 113–119. [Google Scholar] [CrossRef]
- Dhillon, M.K.; Kumar, S. Amino acid profiling of Sorghum bicolor vis-à-vis Chilo partellus (Swinhoe) for biochemical interactions and plant resistance. Arthropod-Plant Interact. 2017, 11, 537–550. [Google Scholar] [CrossRef]
- Bach-Pages, M.; Preston, G.M. Methods to quantify biotic-induced stress in plants. Methods Mol. Biol. 2017, 19, 241–255. [Google Scholar] [CrossRef]
- Walther, M.; Wagner, I.; Raschke1, J.; Zoglauer, K.; Rupps, A. Abscisic acid induces somatic embryogenesis and enables the capture of high-value genotypes in Douglas fir (Pseudotsuga menziesii [MIRB.] Franco). Plant Cell Tissue Organ Cult. 2022, 148, 45–59. [Google Scholar] [CrossRef]
- Tang, Q.Y. Data Processing System-Experimental Design, Statistical Analysis and Data Mining (Second Edition). 2010. Available online: www.sciencep.com (accessed on 7 October 2023).
- Wang, G.; Liu, Y.T.; Wang, J.B.; Li, H.L. Study on the optimization of amino acids on proliferation of calli and somatic embryogenesis in Litchi chinensis Sonn. cv. Feizixiao. J. Fruit Sci. 2023, 40, 2466–2476. [Google Scholar] [CrossRef]
- Malabadi, R.B.; Van Staden, J. Somatic embryogenesis from vegetative shoot apices of mature trees of Pinus patula. Tree Physiol. 2005, 25, 11–16. [Google Scholar] [CrossRef] [PubMed]
- Niemenak, N.; Saare-Surminski, K.; Rohsius, C.; Ndoumou, D.O.; Lieberei, R. Regeneration of somatic embryos in Theobroma cacao L. in temporary immersion bioreactor and analyses of free amino acids in different tissues. Plant Cell Rep. 2008, 27, 667–676. [Google Scholar] [CrossRef]
- Murch, S.J.; Victor, J.M.R.; Krishnaraj, S.; Saxena, P.K. The role of proline in thidiazuron-induced somatic embryogenesis of peanut. Vitr. Cell. Dev. Biol. Plant. 1999, 35, 102–105. [Google Scholar] [CrossRef]
- Martínez, M.T.; San José, M.C.; Vieitez, A.M.; Cernadas, M.J.; Ballester, A.; Corredoira, E. Propagation of mature Quercus ilex L. (Holm Oak) trees by somatic embryogenesis. Plant Cell Tissue Organ Cult. 2017, 131, 321–333. [Google Scholar] [CrossRef]
- Von Arnold, S. Improved efficiency of somatic embryogenesis in mature embryos of Picea abies (L.) Karst. J. Plant Physiol. 1987, 128, 233–244. [Google Scholar] [CrossRef]
- Zavattieri, M.A.; Frederico, A.M.; Lima, M. Induction of somatic embryogenesis as an example of stress-related plant reactions. Electron. J. Biotechnol. 2010, 13, 12–13. [Google Scholar] [CrossRef]
- Pinto, G.; Valentim, H.; Costa, A.; Castro, S.; Santos, C. Somatic embryogenesis in leaf callus from a mature Quercus suber L. Tree. Vitr. Cell. Dev. Biol.-Plant 2002, 38, 569–572. [Google Scholar] [CrossRef]
- Barrett, J.D.; Park, Y.S.; Bonga, J.M. The effectiveness of various nitrogen sources in White Spruce [Picea glauca (Moench) Voss] Somatic Embryogenesis. Plant Cell Rep. 1997, 16, 411–415. [Google Scholar] [CrossRef] [PubMed]
- Daniel, M.A.; Host, A.D.R.; Antony, C.S.; Ramakrishnan, M.; Duraipandiyan, V.; Ignacimuthu, S.; Al-Dhabi, N.A. Effect of L-glutamine and casein hydrolysate in the development of somatic embryos from cotyledonary leaf explants in Okra (Abelmoschus esculentus L. Monech). South Afr. J. Bot. 2018, 114, 223–231. [Google Scholar] [CrossRef]
- Ashok, K.H.G.; Murthy, H.N. Effects of sugars and amino acids on androgenesis of Cucumis sativus. Plant Cell Tissue Organ Cult. 2004, 78, 201–208. [Google Scholar] [CrossRef]
- Pintos, B.; Manzaneraj, A.; Bueno, M.A. Oak somatic and gametic embryos maturation is affected by charcoal and specific amino acids mixture. Ann. For. Sci. 2010, 67, 205. [Google Scholar] [CrossRef][Green Version]
- Kong, Y.Y.; Biddle, J.; Kalaipandian, S.; Adkins, S.W. Coconut callus initiation for cell suspension culture. Plants 2023, 12, 968. [Google Scholar] [CrossRef] [PubMed]
- Maruyama, T.E.; Ueno, S.; Mori, H.; Kaneeda, T.; Moriguchi, Y. Factors influencing somatic embryo maturation in Sugi (Japanese Cedar, Cryptomeria japonica (Thunb. ex L.f.) D. Don). Plants 2021, 10, 874. [Google Scholar] [CrossRef] [PubMed]
Disclaimer/Publisher’s Note: The statements, opinions and data contained in all publications are solely those of the individual author(s) and contributor(s) and not of MDPI and/or the editor(s). MDPI and/or the editor(s) disclaim responsibility for any injury to people or property resulting from any ideas, methods, instructions or products referred to in the content. |
© 2023 by the authors. Licensee MDPI, Basel, Switzerland. This article is an open access article distributed under the terms and conditions of the Creative Commons Attribution (CC BY) license (https://creativecommons.org/licenses/by/4.0/).